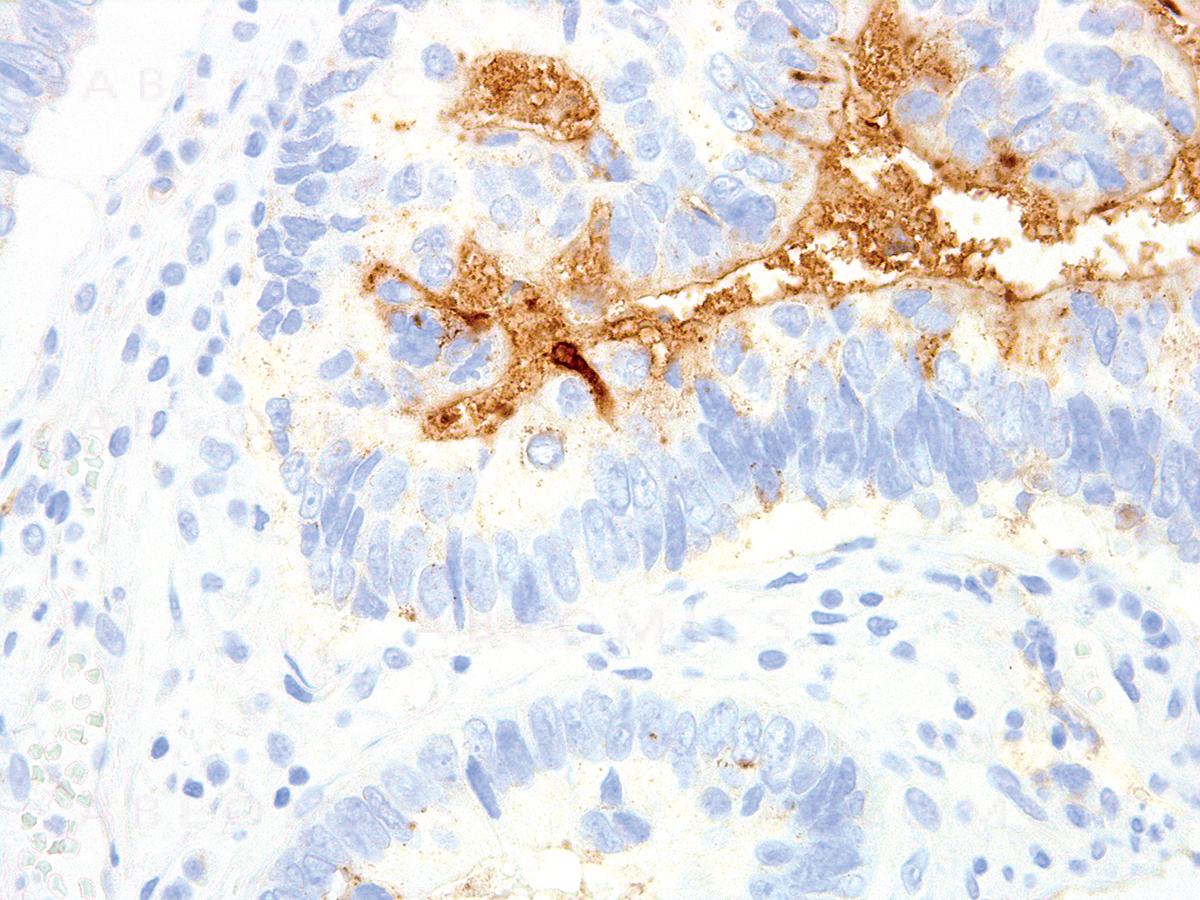

Anti-TAG-72 Monoclonal Antibody (Clone:IHC072)
Figure 1: Immunohistochemical analysis of TAG-72 (Clone: IHC072) on Colon
Roll over image to zoom in
Shipping Info:
For estimated delivery dates, please contact us at [email protected]
Format : | Purified |
Amount : | 0.5 ml |
Isotype : | Mouse IgG1, kappa |
Purification : | Protein A/G Chromatography |
Content : | Tris Buffer, pH 7.3 - 7.7, with 1% BSA and <0.1% Sodium Azide |
Storage condition : | Store at 2°C - 8°C. Do not freeze. |
Tumor-Associated Glycoprotein 72 (TAG-72) is a glycoprotein found on the surface of many cancer pathologies. Anti-TAG-72 can be useful for detecting some adenocarcinomas and non-neoplastic tissues.
Recommended dilutions: Immunohistochemical analysis: 1:100 - 1:200. However, this need to be optimized based on the research applications.
For Research Use Only. Not for use in diagnostic/therapeutics procedures.
There are currently no product reviews
|